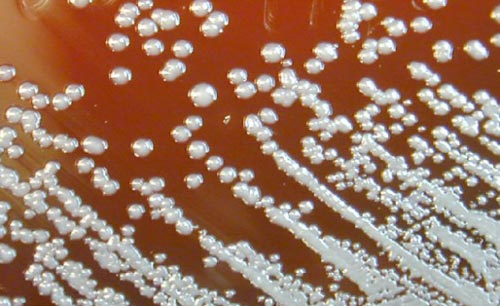

1.消除传染源 首先要消灭马类间鼻疽的流行。
(1)检测:应用鼻疽菌素滴眼试验,可以鉴别出感染和未感染的马匹,即将鼻疽菌素滴入马眼结膜囊内,于滴眼后的第3,6,9,24h观察反应,如发生结膜炎,并分泌脓性眼眵者为阳性反应。
(2)隔离:根据检测结果,将马属动物群分为患病群、疑似感染群和假定健康群三类。隔离观察疑似感染群、假定健康群,经6个月观察,不再发病方可解除隔离。曾与病畜接触的马匹,即使其眼试验阴性者,亦应隔离3周观察。
(3)扑杀:已证明受感染的马类,不论其症状有无,都应在不放血条件下立即处死,并深埋。
2.清除传染途径:对污染的马厩杂物应用含氯石灰等彻底消毒。污染的垫料及粪便等采取堆积泥封发酵、高温等方法处理后方可使用。
3.保护易感人群:对从事马匹工作的人,进行预防知识的教育,对患者应特别注意排泄物及污染物的消毒。对从事鼻疽杆菌检验的实验室工作者,必须注意无菌操作与消毒。对可疑受染者进行医学观察3周。发现病人时,应在严格条进下进行治疗,痊愈后方能出院。